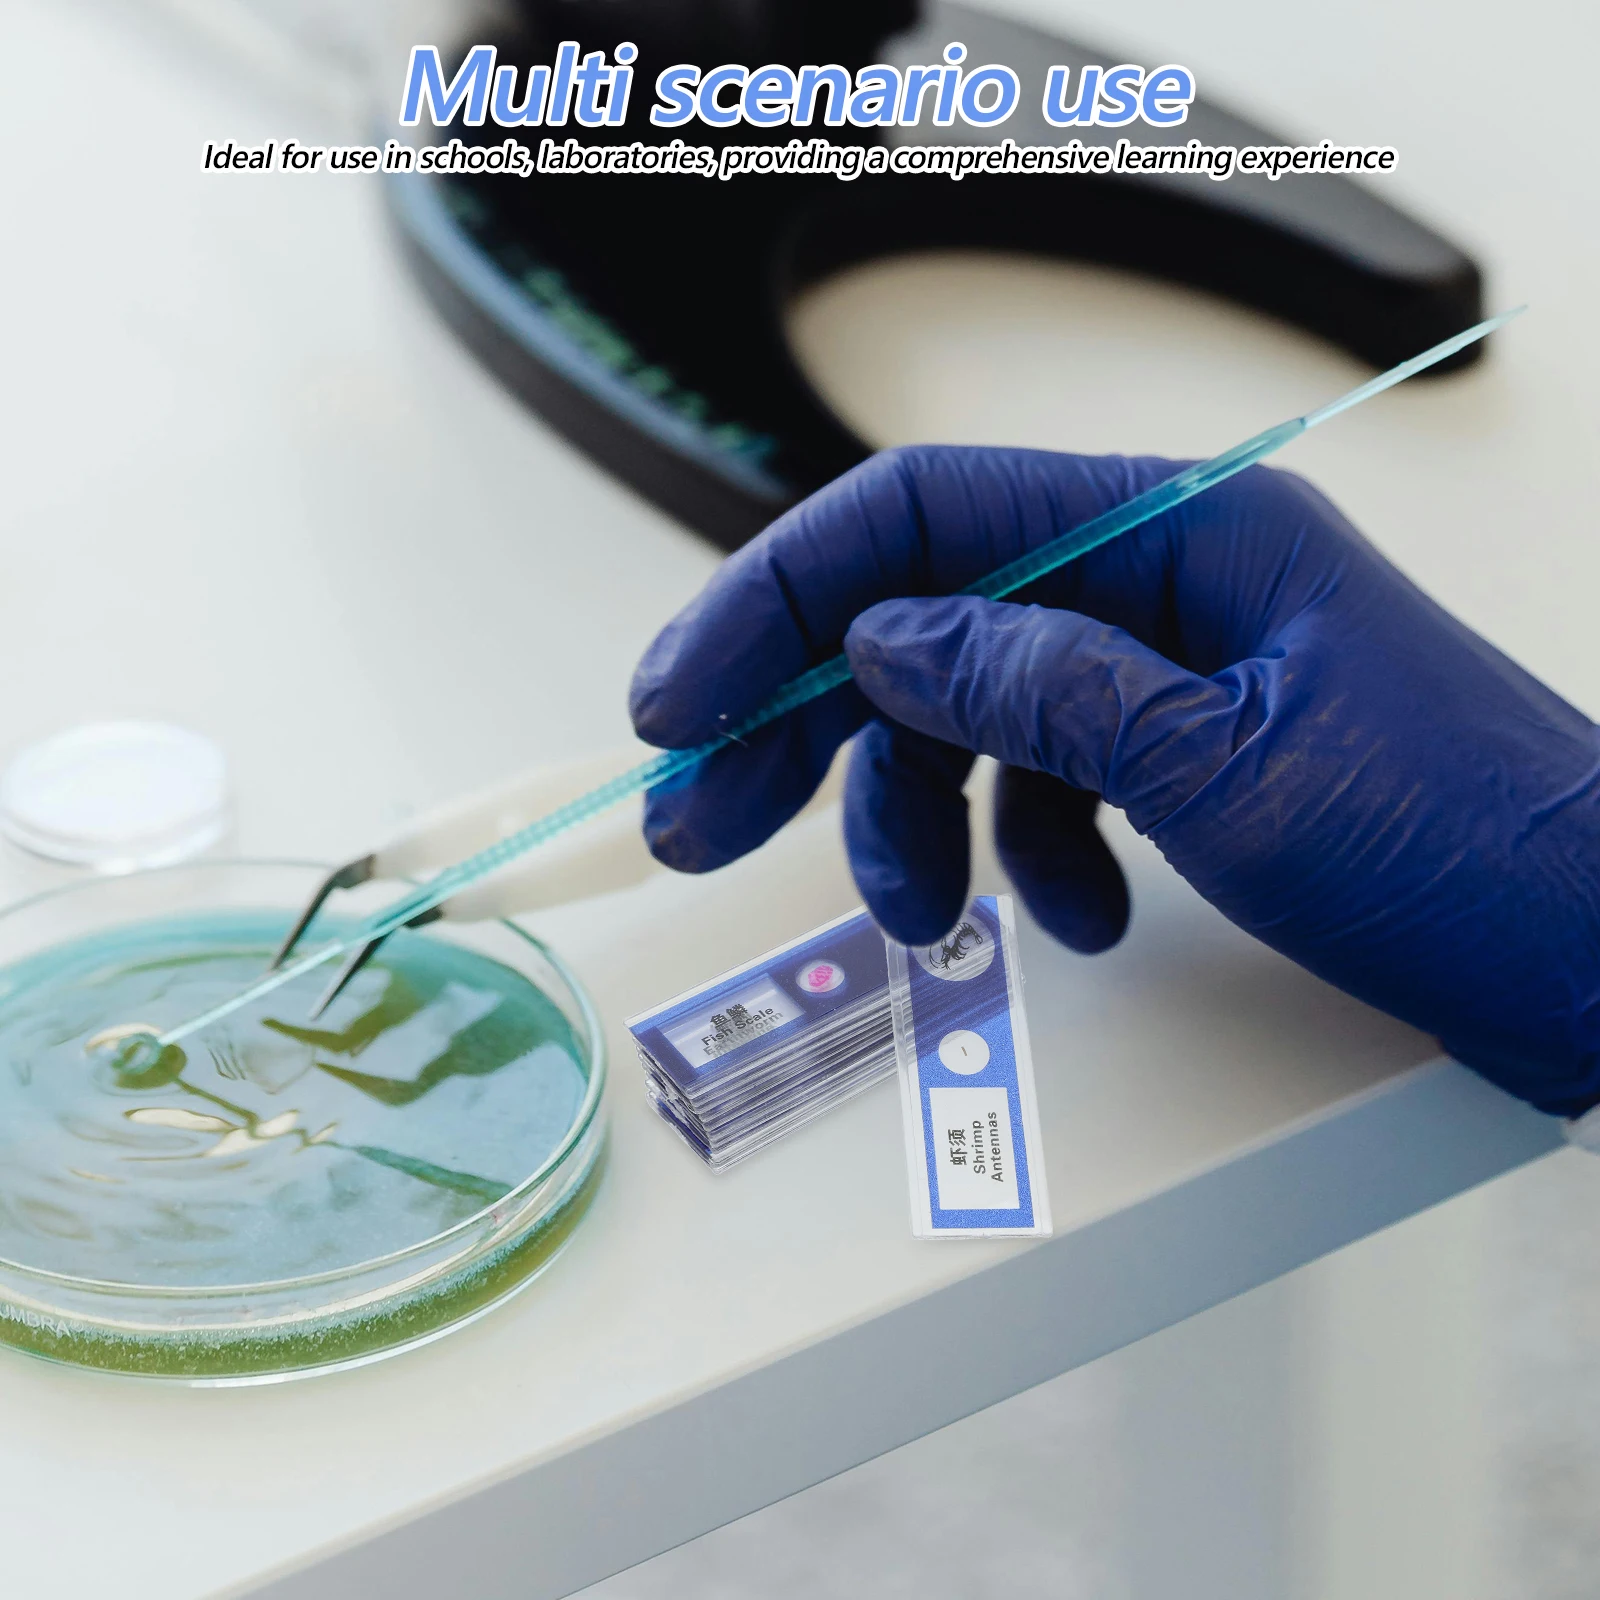

Асимметрическое платье для выпускного с поясом на одно плечо, Зелёный
Описание
Зелёный Очаровательный Без рукавов Полиэстер Одноцветный Платье A-силуэт Легкий Эластичный Все Платья подружек невесты, size features are:Bust: ,Length: длинно ,Sleeve Length:Без рукавов
Характеристики
| Color: | Зелёный |
| gender: | female |
График изменения цены & курс обмена валют
Пользователи также просматривали

378.61 руб.
Пояс с широким ремнем для женщин, женский модный однотонный ремень, украшение для платья, пояс для женщин
aliexpress.ru
29,713.97 руб.
Multi-angle Digital Gloss meter 75 Angles AG-107B testing instrument for Ink paint wood marble polishing brick paper
aliexpress.com
1,181.71 руб.
Zinc Alloy Car Key Case Cover Fashion Sport Car Shape Keychain for Audi A6 A4 A3 Q3 Q5 Q7 A7 A8 Car Accessories Interior
aliexpress.com
2,890.35 руб.
Rear Tailgate Struts for Proton Persona C90 C95 C96 C97 C98 C99 Hatchback Trunk Boot Lift Supports Rod Back Stay Shock Absorber
aliexpress.com
186.02 руб.
20mm Silicone Watchband Strap For Garmin Forerunner 245 645 /Vivoactive 3 Venu 2 Plus SQ Forerunner 55 158 Vivomove HR Wristband
aliexpress.com
2,193.78 руб.
Thickened Non-stick Die Head Coating Non-stick Hot Melt Machine Heat Capacity Die Head Hot Melter Mold
aliexpress.com
1,061.24 руб.
Sleeplion 12V 2CH 433MHz Remote Control Switch Digital Remote Control Switch 12V 2CH 315Mhz/433MHz Module Light Electric Door
aliexpress.com
232.74 руб.
4.5'' LCD Display Touch Screen For Huawei Ascend G510 G520 G525 G525-U00 U8951 T8951 Touchscreen Panel Digitizer Front Glass
aliexpress.com
381.88 руб.
1PC Folderable Plastic 3Pairs False Eyelashes Case Storage Mirror Magnetic Non Magnet Eye Lashes Box Organizer Makeup Tools
aliexpress.com
1,961.89 руб.
Oude mensen Modieus Casual Street Style Voor heren 3D-afdrukken T-shirt Henley-shirt Straat Dagelijks Uitgaan T-shirt Leger Groen Donkerblauw Donkergrijs Korte mouw Henley Overhemd Lente zomer Kleding
lightinthebox.com
670.00 руб.
Сплошная цветная шапочка для малышей, эластичная фуражка, милые зимние детские шапки для новорожденных
joom.ru
17,911.23 руб.
shopping bag composite bags handbag plain letter printing whole skin embossing grain genuine leather detachable zipper purse string high qua
dhgate.com
8,985.06 руб.
basketball shoes sneakers trainers dark bred sports hyper royal aurora green cap and gown 13 women men 13s size us 5.5-13cheap
dhgate.com
2,424.88 руб.
Dress Shoes Mens Casual Hightop Shoes Fashion Men Tennis Blue Black Breathable Canvas Sneakers Male Trainers Skateboard Trend Tides Shoes 220921, White
dhgate.com
10,793.53 руб.
Sunshine Handbag Crossbody Bags Cowhide Leather Hawksbill Handle Baroque Print Removable Shoulder Strap Fashion Letters Women Tote Shopping, 35x17x31cm
dhgate.com
924.39 руб.
soft clound flip flops men slides shoes indoor home platform slipper female summer beach nonslip sandals 220708, Black
dhgate.com
7,162.46 руб.
2021 men women slipper summer fashion flowers floral brocade rubber wide flat slide beach causal sandals flip flops3134, Black
dhgate.com
1,493.93 руб.
2021s knits hats for men sport with beanie women bonnet wool knitted knit hat gorro skullies warm rangers winter hat pom-pom313k, Blue;gray
dhgate.com
813.76 руб.
Motorbike Handlebar Bracket 22mm Mobile Phone Fit for Honda Rebel1100 Rebel 250
aliexpress.com
4,537.53 руб.
brand designer CD Clothing Sets white pullover+ Net half skirt bear printing childrens autumn long sleeve tracksuit boys wear size 100-150, Customize
dhgate.com
4,058.94 руб.
Набор для творчества из бумаги с изображением бабочки и клёстков, набор из крафт-бумаги для клёстков, домашний декор, 3D Оригами-коллажи, опто...
aliexpress.ru
2,905.10 руб.
2020 summer men sandals leather vintage flat heel solid buckle beach gladiator sandals shoes breathable men flip flops, Black
dhgate.com
5,654.50 руб.
Godox TT600 2.4G Wireless Camera Flashes Speedlite With X1T-N Transmitter for Nikon D3200 D3300 D5300 D7200 D750 D90 Gift Kit
aliexpress.com
1,756.17 руб.
dumbbell barbell grips thick bar fat handle pull up weightlifting support silicone anti-slip protect pad for fitness body buildi
dhgate.com
770.32 руб.
GUDI 9610-9615 Amusement Park Burger Shop Ferris Wheel Pirate Ship Building Set Classic DIY Educational Toys For Kids
aliexpress.com
6,023.27 руб.
Ciszean 5x 3.75V 9000mAh P8110 SP3496A8H Battery For Samsung Google Nexus 10 GT-P8110 P8110 HA32ARB Table Batteria Battereis
aliexpress.com
34,303.95 руб.
USPS to USA S0295 Tibet Buddhism Folk Copper Bronze gild Four-armed Avalokitesvara Buddha Statue
aliexpress.com
53,003.93 руб.
AOONAV 12.1 inch vertical screen car GPS Multimedia player for-Lexus ES ES240 ES350 2006-2012 radio DVD player
aliexpress.com
7,549.16 руб.
New OEM C4719A C4714-60146 C4714-69146 for DesignJet 430 450C 455CA 488CA Rollfeed KIT plotter parts E/A0 36 inch
aliexpress.com
4,130.24 руб.
Nordic LED Pendant Lights Minimalist Home Decor Living Room Bedroom Indoor Lighting Luster Loft Pendant Lamp Kitchen Fixtures
aliexpress.com
5,581.56 руб.
TAMPROAD Outdoor Solar LED Reflector Light 60LED Infrared PIR Motion Sensor Floodlights Spotlights Flashlights Outside Wall Lamp
aliexpress.com
393.36 руб.
5 Rolls 15mm x 10m DIY Adhesive Washi Gold Embossing Dies for Scrapbooking Tapes, Pink
aliexpress.com